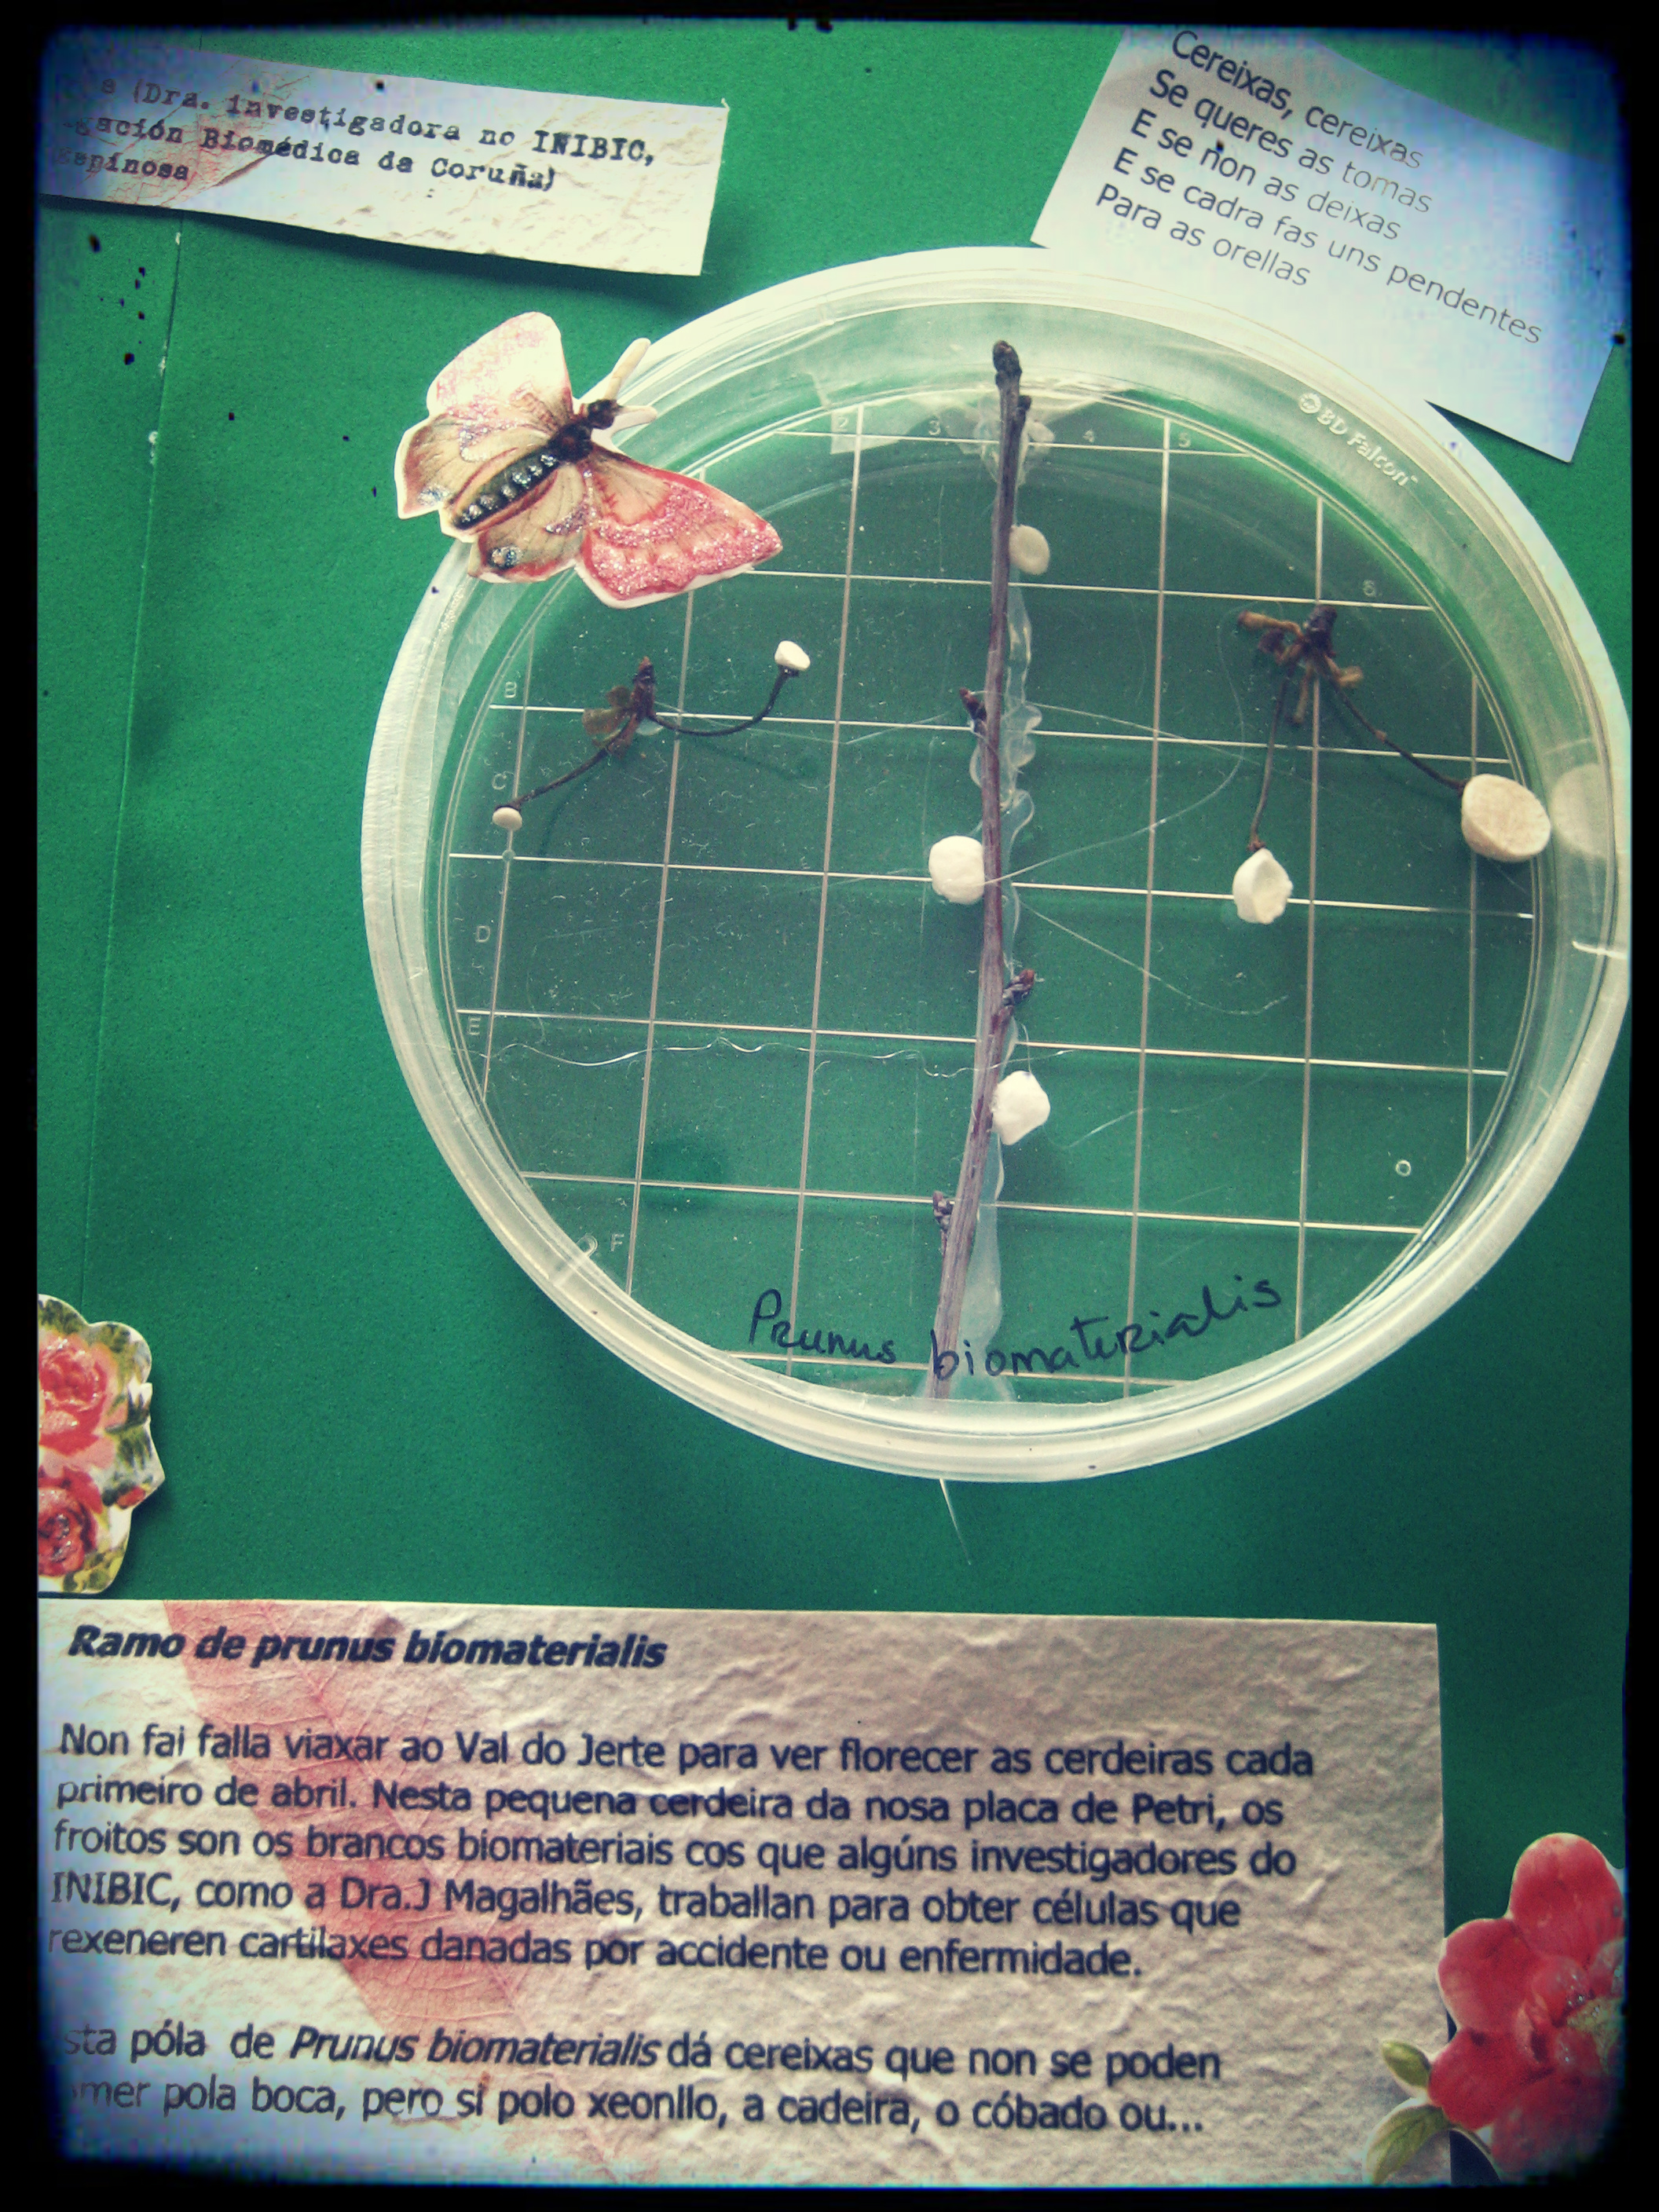

O pasado 10 de maio celebrouse no Parque de Santa Margarida da Coruña o XIX Día da Ciencia na Rúa, cada ano que pasa máis cheo de globos, nenos e música de coches de choque [por favor, por que?]. Asistira como paseanta a moitas das anteriores edicións, pero este ano participei tamén como colaboradora na haima do INIBIC [Instituto de Investigación Biomédica de A Coruña] e podo dicir que nas fotos que me tiraron a última hora parece que me pasara un camión cisterna por riba. E iso que non tiña responsabilidade nin coordinación de haima ningunha, só puña un minúsculo gran de area. Pero resulta tan fascinante como agotador botar alí o día, dou fe.
Quen si tiña responsabilidade na coordinación das actividades da haima do INIBIC foi a miña anfitrioa, a Dra. Joana Magalhães, e ela si, tamén dou fe, acabou desfondada tras o día e logo do subidón de adrenalina que supuxo ir detrás do tipo que mangou un bolso mentres estabamos recollendo. Que haberá moit@ amig@ da ciencia ao longo do día, non digo que non, mais a última hora chegan os voitres amigos do alleo, a ver se cae algo entre a confusión e a canseira.
No medio dun exuberante programa de manualidades, piñatas, conferencias e visionado de microscopios, Joana e mais eu presentamos unha serie conxunta de Placas de Petri Inter-vidas: por un lado unha intervención de arte e literatura en 5 placas e por outra a lectura do que chamamos Placas de Petri Sonoras, dous textos relacionados coa xeración de formas de vida, criaturas e tecidos. Estes retransmitíronse en Cuac FM e na Cadena Ser o mesmo día. Os fragmentos escollidos foron retallos e corcosidos de Frankenstein, de Mary Shelley, e un anaco dunha charla de Richard Feynman, titulada O valor da ciencia.
Neste audio está toda a retransmisión da radio comunitaria da Coruña Cuac FM. e entre o minuto 9:20 e o 26 a parte das Placas de Petri Sonoras e a entrevista de Isa Lema a Joana Magalhães, sen desperdicio.
http://www.ivoox.com/especial-cuac-fm-xix-dia-da-ciencia-na_md_3104021_1.mp3″ <a href=”http://www.ivoox.com/especial-cuac-fm-xix-dia-da-ciencia-na-audios-mp3_rf_3104021_1.html” title=”Especial CUAC FM XIX Día da Ciencia na rúa.”>Ir a descargar</a>
Os audios que nos gravaron na Cadena Ser [ grazas a Marcos Sanluis por brindarnos o espazo e a Jose ? nos controis] están escoitables e descargables aquí, na versión galega e castelá, respectivamente:
http://estibalizespinosa.bandcamp.com/album/placas-de-petri-sonoras
E aquí abaixo podedes curiosear nas Placas de Petri, os microcosmos en carne viva que expuxemos na haima do INIBIC de 15 a 19 h. e que dan conta da integración dos biomateriais sintéticos [cos que traballa xente como a dra. Magalhães no eido da rexeneración tisular] e criaturas vivas como plantas ou salamántigas. A intención destas placas é deixar clara a arte da rexeneración e o seu vínculo co mundo natural, como na biónica. Ou xogar a alternar o natural e o artificial, indistinguibles ás veces como os pétalos dunha margarida. En todas as placas [agás a da tinta] a arte é de Joana Magalhães, mentres que eu me encarguei de nomear esas novas criaturas híbridas e describilas un pouco.

Aquí abaixo, fotografías do que poderían ser planetas afastados ou satélites por descubrir… e trátase en realidade de tecidos do pulmón, do pulmón fumador, da arteria con ou sen colesterol…

Xusto a carón da haima dos microscopios do INIBIC plantaron a haima dos telescopios da Agrupación Astronómica Ío, cun precioso foguete vermello como o que levou a Tintín á lúa como benvida e outras cousiñas como esta:

Uns días antes, Joana e eu graváramos na Cadena Ser Radio Coruña:


Máis da nosa teima coas placas de Petri e outras cuestións arte::ciencia::literatura aquí:
https://estibalizes.wordpress.com/2013/06/20/joana-in-vivo-1/
e aquí:
https://estibalizes.wordpress.com/2013/06/20/joana-in-vivo-2/
e aquí:
https://estibalizes.wordpress.com/2013/06/20/joana-in-vivo-3/

Máxico, todo.
Grazas!!